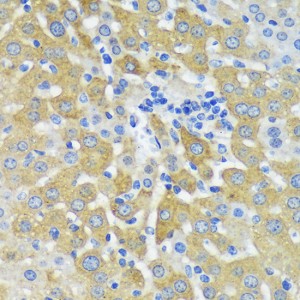
KO-Validated MAP2K4 Rabbit pAb (20 μl)

KO-Validated MAP2K4 Rabbit pAb (20 μl)
| Reactivity: | Human, Mouse, Rat |
| Applications: | WB, IHC, ELISA |
| Host Species: | Rabbit |
| Isotype: | IgG |
| Clonality: | Polyclonal antibody |
| Gene Name: | mitogen-activated protein kinase kinase 4 |
| Gene Symbol: | MAP2K4 |
| Synonyms: | JNKK; MEK4; MKK4; SEK1; SKK1; JNKK1; SERK1; MAPKK4; PRKMK4; SAPKK1; SAPKK-1; K4 |
| Gene ID: | 6416 |
| UniProt ID: | P45985 |
| Immunogen: | Recombinant fusion protein containing a sequence corresponding to amino acids 300-399 of human MAP2K4 (NP_003001.1). |
| Dilution: | WB 1:500-1:2000; IHC 1:50-1:100 |
| Purification Method: | Affinity purification |
| Concentration: | 2.12 mg/ml |
| Buffer: | PBS with 0.02% sodium azide, 50% glycerol ,pH7.3. |
| Storage: | Store at -20°C. Avoid freeze / thaw cycles. |
| Documents: | Manual-MAP2K4 polyclonal antibody |
Background
This gene encodes a member of the mitogen-activated protein kinase (MAPK) family. Members of this family act as an integration point for multiple biochemical signals and are involved in a wide variety of cellular processes such as proliferation, differentiation, transcription regulation, and development. They form a three-tiered signaling module composed of MAPKKKs, MAPKKs, and MAPKs. This protein is phosphorylated at serine and threonine residues by MAPKKKs and subsequently phosphorylates downstream MAPK targets at threonine and tyrosine residues. A similar protein in mouse has been reported to play a role in liver organogenesis. A pseudogene of this gene is located on the long arm of chromosome X. Alternative splicing results in multiple transcript variants.
Images
 | Western blot analysis of various lysates using [KO Validated] MAP2K4 Rabbit pAb (A14781) at 1:1000 dilution. Secondary antibody: HRP-conjugated Goat anti-Rabbit IgG (H+L) (AS014) at 1:10000 dilution. Lysates/proteins: 25μg per lane. Blocking buffer: 3% nonfat dry milk in TBST. Detection: ECL Basic Kit (RM00020). Exposure time: 90s. |
 | Western blot analysis of lysates from wild type (WT) and MAP2K4 knockout (KO) HeLa cells, using [KO Validated] MAP2K4 Rabbit pAb (A14781) at 1:1000 dilution. Secondary antibody: HRP-conjugated Goat anti-Rabbit IgG (H+L) (AS014) at 1:10000 dilution. Lysates/proteins: 25μg per lane. Blocking buffer: 3% nonfat dry milk in TBST. Detection: ECL Basic Kit (RM00020). Exposure time: 5s. |
 | Western blot analysis of lysates from A-549 cells, using MAP2K4 Rabbit pAb (A14781) at 1:1000 dilution. Secondary antibody: HRP-conjugated Goat anti-Rabbit IgG (H+L) (AS014) at 1:10000 dilution. Lysates/proteins: 25μg per lane. Blocking buffer: 3% nonfat dry milk in TBST. Detection: ECL Basic Kit (RM00020). Exposure time: 30s. |
 | Western blot analysis of various lysates, using MAP2K4 Rabbit pAb (A14781) at 1:1000 dilution. Secondary antibody: HRP-conjugated Goat anti-Rabbit IgG (H+L) (AS014) at 1:10000 dilution. Lysates/proteins: 25μg per lane. Blocking buffer: 3% nonfat dry milk in TBST. Detection: ECL Basic Kit (RM00020). Exposure time: 30s. |
 | Western blot analysis of lysates from HeLa cells, using MAP2K4 Rabbit pAb (A14781) at 1:700 dilution. Secondary antibody: HRP-conjugated Goat anti-Rabbit IgG (H+L) (AS014) at 1:10000 dilution. Lysates/proteins: 25μg per lane. Blocking buffer: 3% nonfat dry milk in TBST. Detection: ECL Basic Kit (RM00020). Exposure time: 60s. |
 | Immunohistochemistry analysis of paraffin-embedded Mouse liver using MAP2K4 Rabbit pAb (A14781) at dilution of 1:100 (40x lens). Microwave antigen retrieval performed with 0.01M PBS Buffer (pH 7.2) prior to IHC staining. |
 | Immunohistochemistry analysis of paraffin-embedded Rat ovary using MAP2K4 Rabbit pAb (A14781) at dilution of 1:100 (40x lens). Microwave antigen retrieval performed with 0.01M PBS Buffer (pH 7.2) prior to IHC staining. |
 | Immunohistochemistry analysis of paraffin-embedded Mouse kidney using MAP2K4 Rabbit pAb (A14781) at dilution of 1:100 (40x lens). Microwave antigen retrieval performed with 0.01M PBS Buffer (pH 7.2) prior to IHC staining. |
You may also be interested in: